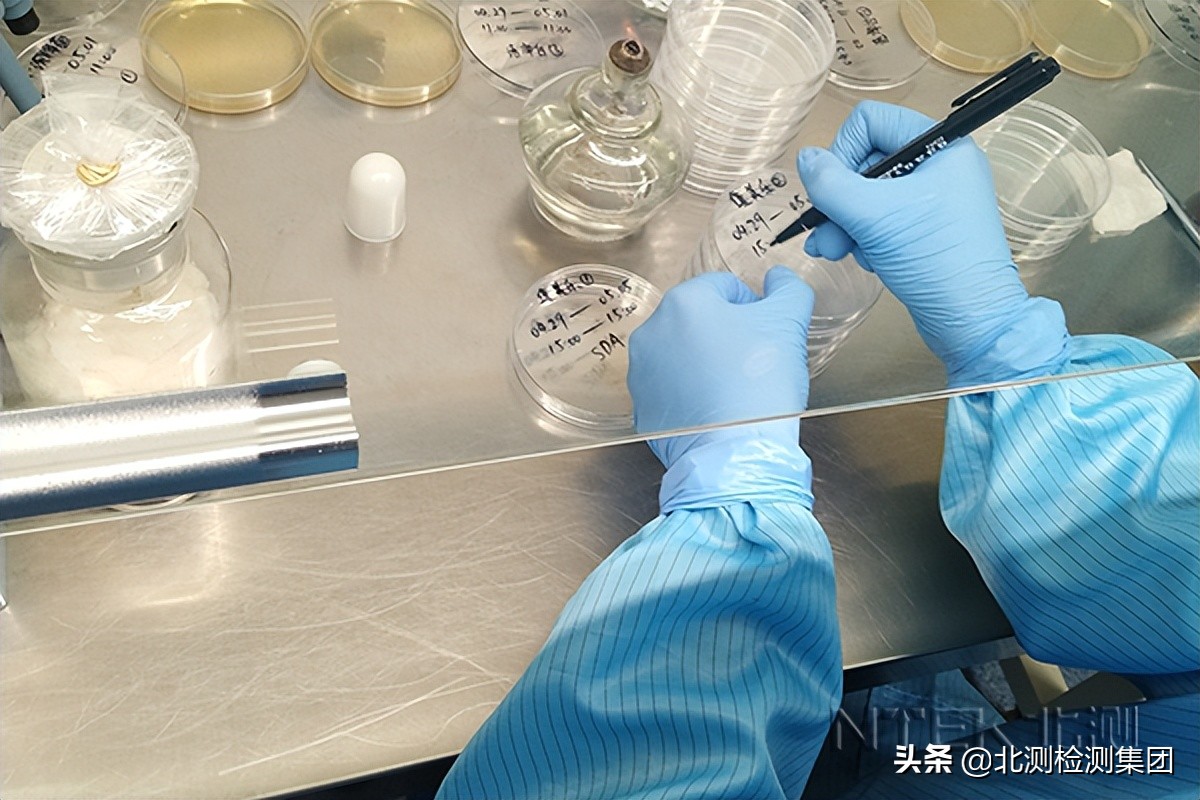
霉菌检测报告办理指南

项目介绍
霉菌是在自然界分布很广的一种微生物,它广泛存在于土壤、空气中。霉菌试验是气候环境试验中的一个项目,用于考核食品、产品或材料抵抗霉菌侵蚀的能力。它与一般环境试验一样,选择产品在实际运输、存储或使用过程中最易遭受霉菌危害的环境条件,在实验室中用人工模拟的方法创造该环境条件并进行试验。
霉菌检测
测试范围
日化用品、电子产品、一次性卫生用品、塑胶材料、油漆油墨、涂层、纺织品、皮革等。
测试目的
霉菌检测用于确定:
(1)产品、设备或组件是否长霉;
(2)霉菌在产品、设备上的生长速度;
(3)霉菌在产品、设备上生长后对装备及其任务完成和使用安全性的影响;
(4)设备能否在环境中有效存储;
(5)若有霉菌生长,有无简单的去除方法。
霉菌测试是确保设计和制造的产品和设备符合防霉要求的最有效手段。尽管设计时已考虑使用防霉材料,但往往不可能完全避免长霉,必须进行霉菌试验,检验其是否真正符合要求。对于尚在研制过程中的产品,霉菌试验的结果可作为改进产品耐霉菌设计的依据,对于设计定型的产品,霉菌试验可作为产品是否符合设计要求、是否能通过设计定型的一个依据,当然也可为日后的改进设计提供信息。 为确定产品抗霉菌侵蚀的能力,必须制定一个与实际工作条件相似并能判断霉菌的侵蚀作用及给出正确评价的试验方法。为产品的选材、结构和设计提供依据,以保证产品能在有大量霉菌存在的气候环境中安全可靠地运行。
测试项目
抗菌性能、抗菌效果、抗细菌性能、抗微生物活性、抗真菌性评价、防霉性能、抗微生物活性、培养基改良实验检测,霉菌消毒效果检测等。
测试流程
1、寄样(或上门取样) 2、免费初检(不收取任何费用) 3、根据实验复杂程度进行报价 4、双方确定,签订保密协议,开始实验 5、完成实验 6、邮寄检测报告,提供后期服务
参考测试标准
AATCC 100-2004 后整理抗菌织物的抗细菌性评价
AATCC 147-2004 织物的抗细菌性评价
JIs L 1902:2008 纺织品抗菌性试验法
GB/T 20944.1-2007 纺织品抗菌性能的评价第一部分 琼脂扩散法
GB/T 20944.2-2007 纺织品抗菌性能的评价第二部分吸收法
GB/T 20944.3-2008 纺织品抗菌性能的评价第三部分振荡法
GB/T 20944.3-2008 纺织品抗菌性能的评价第三部分振荡法
FZ/T 73023-2006 抗菌针织品
QB/T 2881-2013 鞋类内垫和衬里材料抗菌技术条件
ISO 20743:2013 织物品抗菌性能试验方法复合微生物肥料
NY/T 798-2004 FZ/T 62015-2009 抗菌毛巾
ASTM E 2149-2010 在动态接触条件下固定抗菌剂抗菌活性测定的标准实验方法
ATCC 174-1998 (2007) 地毯的抗微生物活性的评估
GB/T 23164-2008 地毯的抗微生物活性测定
SH/T 2162-2008 壳聚糖抗菌棉纺织品检验规程
AATCC 30-2013 织物抗真菌性的评价 抑制织物的霉变
GB/T 24346-2009 纺织品防霉性能的评价
FZ/T 60030-2009 家用纺织品防霉性能测试方法
AATCC 174-1998(2007) 地毯的抗微生物活性的评估
GB/T 23164-2008 地毯的抗微生物活性测定
GB/T 24253-2009 纺织品防螨性能的评价 FZ/T 62012-2009 防螨床上用品